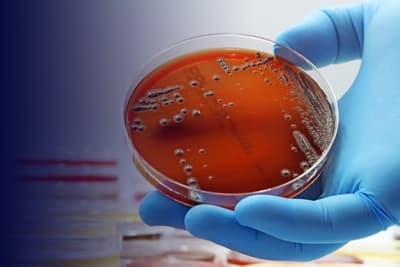
Imagem

EXTENSÃO - EAD

e amplie sua atuação dominando taxonomia, morfologia e fisiologia bacteriana, semeadura e identificação em meios de cultura

.
Aguardamos a definição do(a) coordenador(a) responsável por este curso.

A formação aborda os fundamentos da microbiologia bacteriana, explorando conceitos relacionados à morfologia, estrutura celular, fisiologia microbiana e técnicas laboratoriais aplicadas ao processamento de amostras clínicas. Ao longo do curso, o aluno compreenderá os mecanismos de crescimento, reprodução e identificação bacteriana, fortalecendo conhecimentos essenciais para atuação em análises microbiológicas e laboratoriais.
A trilha também discute meios de cultura, semeadura microbiológica, coleta e transporte de materiais clínicos, além de fatores relacionados à virulência bacteriana e interpretação do crescimento microbiano, proporcionando uma visão técnica e integrada sobre os processos microbiológicos aplicados à saúde.
Público: Livre
A formação aborda os fundamentos da microbiologia bacteriana, explorando conceitos relacionados à morfologia, estrutura celular, fisiologia microbiana e técnicas laboratoriais aplicadas ao processamento de amostras clínicas. Ao longo do curso, o aluno compreenderá os mecanismos de crescimento, reprodução e identificação bacteriana, fortalecendo conhecimentos essenciais para atuação em análises microbiológicas e laboratoriais.
A trilha também discute meios de cultura, semeadura microbiológica, coleta e transporte de materiais clínicos, além de fatores relacionados à virulência bacteriana e interpretação do crescimento microbiano, proporcionando uma visão técnica e integrada sobre os processos microbiológicos aplicados à saúde.
Público: Livre
Nossa equipe é formada por especialistas renomados com ampla experiência acadêmica e prática. Eles estão aqui para orientar, inspirar e transformar sua trajetória profissional.
Na USCS, você encontra um ambiente acadêmico preparado para transformar conhecimento em prática. Nossa proposta é oferecer uma formação de qualidade, com professores experientes, infraestrutura moderna e metodologias que acompanham as demandas do mercado.
Aqui, o estudante é incentivado a desenvolver senso crítico, ampliar suas habilidades e construir uma trajetória sólida, tanto profissional quanto pessoal. Valorizamos a inovação, a pesquisa e a troca de experiências, criando oportunidades para que cada aluno possa explorar seu potencial ao máximo.
Estudar na USCS é investir em aprendizado contínuo, crescimento e novas possibilidades para o futuro.
Se preferir, entre em contato diretamente com nosso time de vendas pelo número (11) 2714-5699 ou clicando no ícone de WhatsApp a seguir:
CONTATO NO WHATSAPPTrabalhamos ao lado de grandes instituições e marcas que compartilham do mesmo propósito: oferecer qualidade, inovação e oportunidades para transformar vidas.